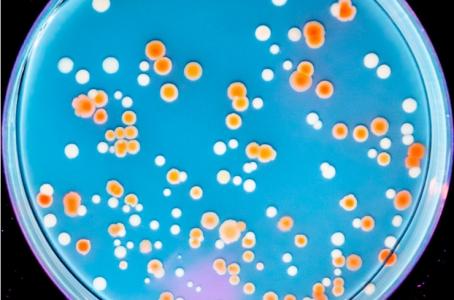
Mais comment la radiorésistance aurait-elle pu évoluer dans plusieurs organismes de notre planète, naturellement protégés du rayonnement solaire par son champ magnétique ? (Visuel Michael M. Cox and coauthors )

RADIORÉSISTANCE : Les bactéries aussi !
Chez les bactéries, on étudie plus l’antibiorésistance que la radiorésistance et pourtant. La radiorésistance évolue dans de nombreux organismes de notre planète, heureusement protégée du rayonnement solaire par son champ magnétique. Si on connaît mal ce phénomène de radiorésistance chez les bactéries, on sait que certaines espèces, dont Deinococcus radiodurans sont particulièrement radiorésistantes. Cette étude, présentée dans la revue Frontiers in Microbiology, montre qu’E coli aussi peut devenir radiorésistante. C’est le début d’un décryptage des gènes en cause dans cette forme de résistance des organismes vivants.
Quels gènes sont spécifiquement impliqués dans la radiorésistance, c’est finalement la question, que se posent ici les auteurs de l’Université du Wisconsin-Madison. Ils induisent une radiorésistance chez E. coli et suivent l’évolution complexe des mutations qui s’accélère au fur et à mesure que le niveau d’exposition augmente.
Ces organismes extrêmophiles
Les organismes les plus résistants sur Terre, appelés extrémophiles, peuvent survivre à des conditions extrêmes telles que la sécheresse extrême (dessiccation), le froid extrême, le vide spatial, l'environnement acide ou des radiations de haut niveau. Jusqu'à présent, la bactérie connue connue comme la plus radiorésistante est Deinococcus radiodurans, une bactérie capable de survivre à des doses de rayonnement mille fois supérieures à celles qui sont mortelles pour l'homme.
Mais comment la radiorésistance aurait-elle pu évoluer dans plusieurs organismes de notre planète, naturellement protégés du rayonnement solaire par son champ magnétique ? Pour répondre à cette question, l'équipe du Dr Cox, de l'Université du Wisconsin-Madison, a décidé de
« laisser parler les cellules».
Les chercheurs ont commencé avec la bactérie naturellement non résistante, E. coli, et l'ont exposée à des cycles itératifs d'irradiation de haut niveau. Après de nombreux cycles d'exposition et une exposition croissante aux radiations, les chercheurs observent l’émergence de certaines populations radiorésistantes. Par séquençage du génome entier, les chercheurs peuvent identifier les altérations génétiques présentes dans chaque population radiorésistante et les mutations porteuses de cette radiorésistance.
Des organismes radiorésistants
Lorsque la bactérie E. coli est exposée à 50 cycles d'ionisation, certaines populations radiorésistantes émergent et l'étude de leur profil génétique met en évidence 3 mutations responsables de cette radiorésistance :toutes ces mutations, sans surprise, concernent des gènes impliqués dans la réparation de l'ADN.
Exposées à nouveau à 50 autres cycles d'exposition aux rayonnements, ces populations d'E. Coli radiorésistantes continuent d’évoluer :
- alors que la radiorésistance induite par la première série d'ionisation apparaît principalement associée à 3 mutations, la seconde a induit des centaines de mutations comprenant des délétions importantes et des duplications de plusieurs gènes ;
- finalement, après de nombreux cycles, E.coli peut atteindre des niveaux de radiorésistance comparables à ceux observés avec Deinococcus radiodurans ;
- et au fur et à mesure des expositions, les altérations génomiques se multiplient et se complexifient. A ce stade, les chercheurs montrent que davantage de métabolismes cellulaires sont affectés (synthèse d'ATP (complexe protéique enzymatique présent dans les mitochondries), biogenèse des clusters fer-soufre, synthèse de cadavérine et réponse des espèces réactives de l'oxygène) ;
- enfin, les chercheurs montrent aussi qu’il est possible d’accroître encore la radiorésistance chez Deinococcus radiodurans.
Il reste beaucoup à comprendre, mais l’objectif est d’ores et déjà la constitution d’une « boîte à outils » des mutations nécessaires à concevoir des probiotiques radiorésistants pouvant par exemple aider les patients traités par radiothérapie
Ou, qui sait, soutenir les astronautes exposés aux rayonnements spatiaux.
